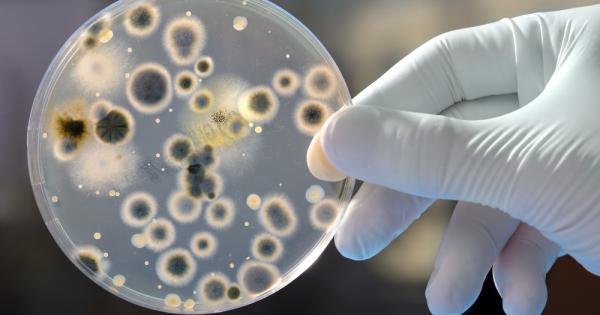
През 2001 ва една пръдлива медицинска сестра задала доста необичаен въпрос

... гъби“ може да облекчи депресията в продължение на 5 години, изследователите намират Търгувах с алкохол за тези вливани напитки и не погледнах назад топ концерти
Болести Разпространяват - Новини
кърлежите се разпространяват извън тяхната зона на комфорт и
...... е асистент за производство на лайфстайл с Fox News Digital. Тя и екипът на Lifestyle обхващат редица истории, включително храна и напитки, пътувания и здраве.
Световната здравна организация СЗО заяви снощи че в Судан е
...... са широко разпространени и в Южен Судан, където в граничния град Ренк също има епидемия от холера и където настаняването на бежанците става все по-трудно.
Световната здравна организация СЗО заяви снощи че в Судан е
...... са широко разпространени и в Южен Судан, където в граничния град Ренк също има епидемия от холера и където настаняването на бежанците става все по-трудно.
Европейският център за контрол и превенция на заболяванията ECDC издаде
...... пренасяните заболявания обикновено са подобни на грип, но могат да се развият до много тежко и дори фатално. Миналата година... Прочетете целия материал в cash.bg
Хан Юнис Газа – Канализацията тече по улиците на Газа
...... питат кога ще свърши войната? Те стоят по улиците и искат бутилки с вода за пиене. Но в Газа няма питейна вода. Източник: Ал Джазира
През 2001 ва една пръдлива медицинска сестра задала доста необичаен въпрос
...... дори могат да бъдат сравнени с онези, „приятелски настроените“, които срещаме в киселото мляко. „Нашето финално заключение? Не пърдете голи край храна“, казва д-р Кружелнички. Източник: IFLScience